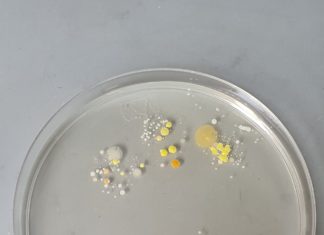
Mikrobiolog-i-ja
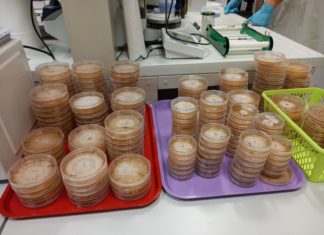
Šumski detektivi

Mikrobiolog-i-ja
Bakterije su posvuda u našem okolišu. Štoviše, prisutne su i u našem tijelu te na površini naše kože gdje su u većini slučajeva jako...
Aquafun: Igraj, otkrij, uči!
Društvene igre pružaju mnoge edukativne prednosti, potičući razvoj kognitivnih, komunikacijskih i socijalnih vještina kod djece. Kroz igru, djeca razvijaju kreativnost, uče o disciplini, organizaciji...
Šumski detektivi
Cilj radionice “Šumski detektivi” je učenicima dati uvid u metode istraživanja biljnih patogena na primjeru fitopatogene gljive Ophiostoma novo-ulmi, uzročnika holandske bolesti brijesta te...
Gdje se skriva famozna vrpca?
Ona je molekula koja nosi uputu za specifični razvoj živih organizama, nalazi se u stanicama, a može biti duža od prosječne visine čovjeka. Ona...
Biološke pustolovine
Biti znanstvenik velika je pustolovina i izazov. Biologija je znanost koja se temelji na opažanju i opisivanju prirodnih pojava koje se ispituju pokusima, a...
Pronađi me ako možeš!
Životinje su tijekom evolucije razvile brojne prilagodbe koje im omogućavaju bolje preživljavanje, a jedna od njih je i mimikrija. Mimikrija je sposobnost životinja da...